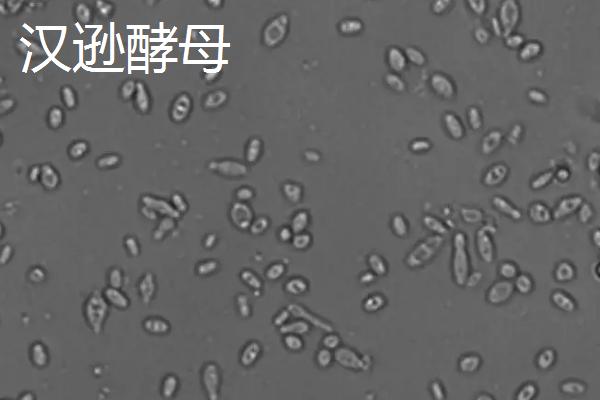
酿酒酵母的无性繁殖是，酿酒酵母和汉逊酵母的区别

酿酒酵母的无性繁殖是芽殖,其中“芽”是指在母体上分出的幼体,而不是高等植物上真正的芽结构。亲代藉由细胞分裂产生子代,在一定部位长出芽体,芽体不会立即脱离母体,而是继续相连并吸收母体的养分,直到个体可以独立生存后才会脱离。
一、酿酒酵母的无性繁殖是
1、酿酒酵母的无性繁殖是出芽生殖,也称芽殖,其中的“芽”是指在母体上分出的幼体,而不是高等植物上真正的芽(萌发的芽)的结构。
2、亲代藉由细胞分裂产生子代,在一定部位长出芽体(即芽基,与母体较相似),芽体不会马上从母体脱离,而是与母体相连,继续吸收母体的养分,直到个体能独立生存时才会脱离。

二、酿酒酵母和汉逊酵母的区别
1、性质不同
(1)酿酒酵母:属于酵母菌属,别称出芽酵母、面包酵母。
(2)汉逊酵母:属于“Hansenula”属,是一种微生物,原产于我国。

2、用途不同
(1)酿酒酵母:可用来酿酒、制作面包和馒头等食物。
(2)汉逊酵母:可用于研究、教学、制作白酒。
3、形态不同
(1)酿酒酵母:菌落呈乳白色(生长在麦芽汁琼脂培养基上),有光泽,平坦,边缘整齐,细胞形状为圆形、卵形、卵圆形,细胞宽度为2.5-10微米,长度为4.5-21微米,长宽比为1-2。
(2)汉逊酵母:细胞呈圆形、椭圆形、腊肠形,直径为4-7微米,多边芽殖、发酵,液面有白色菌醭,培养液较混浊。菌落平坦(生长在麦芽汁斜面上),颜色为乳白色,无光泽,边缘呈丝状,在加盖片的马铃薯葡萄糖琼脂培养基上培养,可生成树状分支的假菌丝,芽生孢子呈圆形、椭圆形。
三农问答